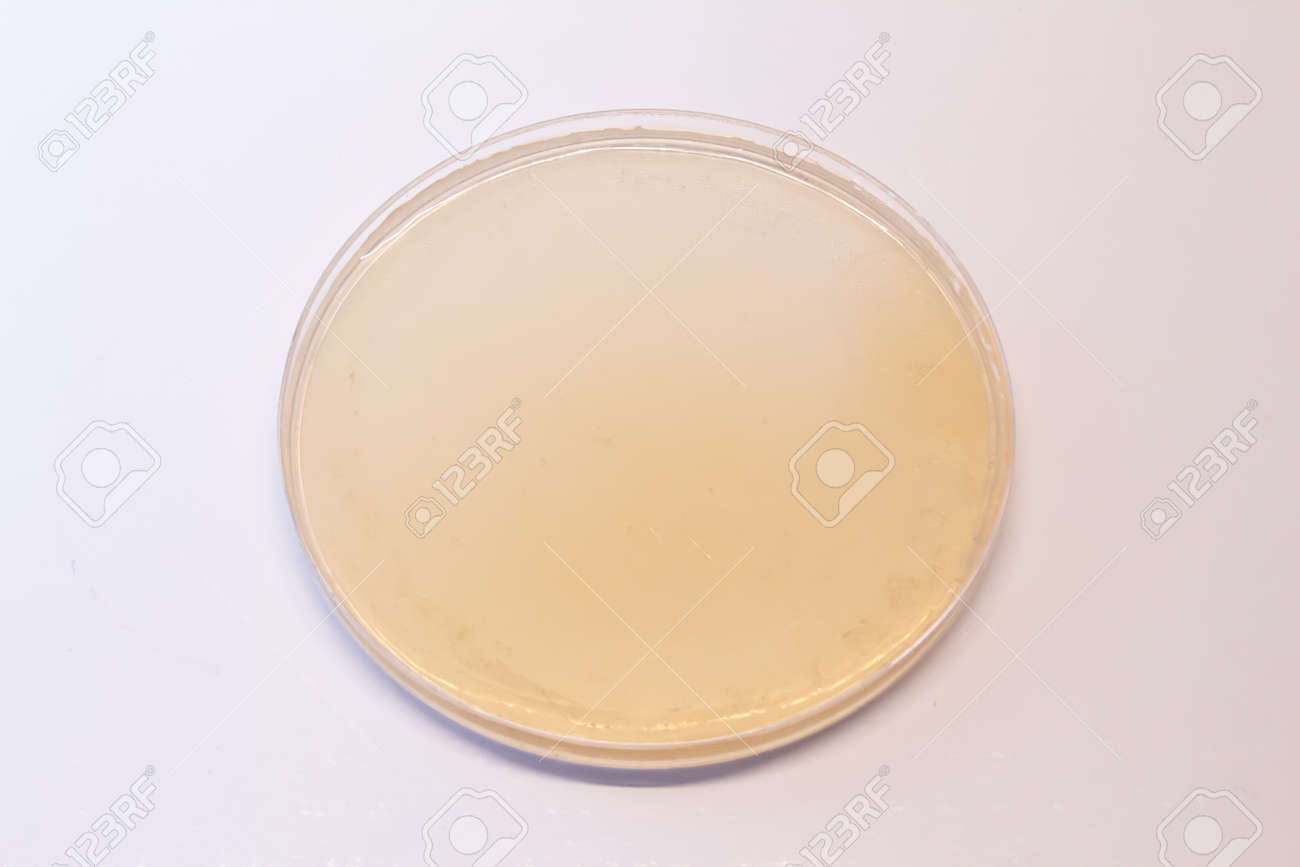
etiam-dictum-ipsum-a-felis

Download
Close
Автор:
id:
Ключевые слова:
agar, biology, biotechnology, blank, care, chemical, chemistry, clean, closeup, concept, culture, dish, empty, equipment, experiment, glass, isolated, lab, laboratory, liquid, macro, medical, medicine, microbiology, moisture, no people, petri, petri dish, pharmaceutical, research, sample, science, science and technology, scientific, serum, test, top, top view, transparent, view, white,





